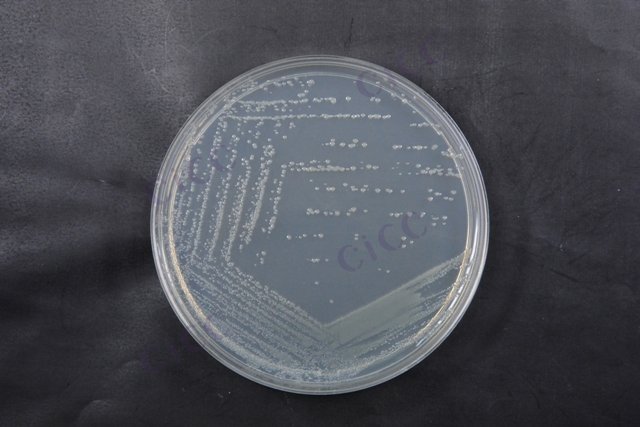
肠道出血性大肠埃希氏菌 Escherichia coli EHEC CICC 24187 Escherichia coli EHEC

肠道出血性大肠埃希氏菌 Escherichia coli EHEC CICC 24187 Escherichia coli EHEC
-
肠道出血性大肠埃希氏菌EHEC Escherichia coli EHEC CICC 25043 Escherichia coli EHEC
CICC 25043 | 见证书
-
肠道出血性大肠埃希氏菌 Escherichia coli EHEC
BNCC345676 | 冻干粉;斜面;菌液;平板
-
肠道致病性大肠埃希氏菌 Escherichia coli EPEC CICC 24189 Escherichia coli EPEC
CICC 24189 | 见证书
-
肠道集聚性大肠埃希氏菌 Escherichia coli EAEC CICC 24186 Escherichia coli EAEC
CICC 24186 | 见证书
-
肠道侵袭性大肠埃希氏菌 Escherichia coli EIEC CICC 24188 Escherichia coli EIEC
CICC 24188 | 见证书
-
肠道出血性大肠埃希氏菌 Escherichia coli EHEC O157:H7 CICC 21530 Escherichia coli EHEC O157:H7
CICC 21530 | 见证书
-
肠道致病性大肠埃希氏菌EPEC Escherichia coli EPEC CICC 25042 Escherichia coli EPEC
CICC 25042 | 见证书

说明书下载: 菌种说明书 打管说明书
您正在浏览的产品:肠道出血性大肠埃希氏菌 Escherichia coli EHEC CICC 24187
手机版:肠道出血性大肠埃希氏菌 Escherichia coli EHEC CICC 24187
本公司销售的所有产品仅供实验科研使用,不用于人体及临床诊断。
1. 前增菌(改良EC肉汤)
2. 选择性分离(麦康凯琼脂)
3. 生化试验(吲哚、MR-VP等)
4. 血清学凝集(O、H抗原检测)[4][3]
2. 样品运输需保持0-4℃并8小时内检测[4][6]
2. 选择性增菌:41.5℃培养18-24小时
3. 显色培养基分离:典型菌落呈蓝绿色金属光泽
4. 毒力基因检测:stx1/stx2毒素基因PCR验证[4][5]
2. 冷冻样品需在45℃水浴中快速解冻
3. 菌株保存应使用含15%甘油的TSB保菌液[4][3]
以上信息仅供参考,请以相应标准的原文为准!